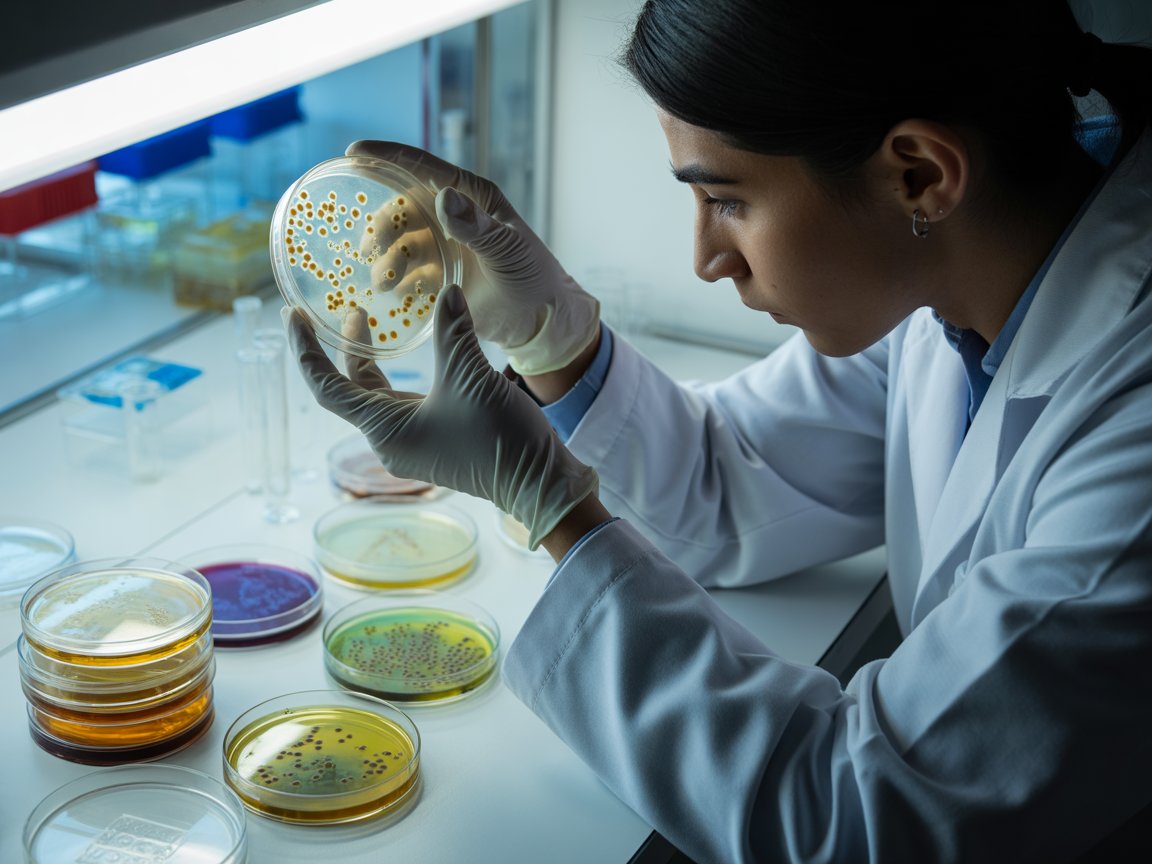

Ученые из УрФУ создали новый антибиотик против супербактерий
Ученые Уральского федерального университета в сотрудничестве с коллегами из Индии и Уральского отделения РАН синтезировали новое вещество с выраженной противовоспалительной и антибактериальной активностью.
Разработка может стать основой лекарств против золотистого стафилококка и других бактерий, устойчивых к современным антибиотикам. Результаты исследования опубликованы в Journal of Molecular Structure.
Химики УрФУ создали восемь новых соединений на основе модифицированных нестероидных противовоспалительных препаратов — ибупрофена и мефенаминовой кислоты, добавив фрагменты азогетероциклов. Два из них показали высокую эффективность при сниженных побочных эффектах.
«Одно из наиболее активных соединений основано на мефенаминовой кислоте, ранее редко применявшейся из-за токсичности. Нам удалось сохранить полезные свойства и снизить побочные эффекты за счёт модификации структуры молекулы», — сообщил профессор кафедры органической и биомолекулярной химии УрФУ Григорий Зырянов.
По словам учёного, новые вещества обладают двойным действием — подавляют воспаление и облегчают боль. При тестировании на кишечной и сенной палочках, золотистом стафилококке и клебсиеллах пневмонии наилучший эффект был отмечен именно против стафилококка.
Сравнение показало, что новые соединения действуют эффективнее диклофенака при меньших концентрациях и демонстрируют схожую активность с гентамицином. Первичные анализы токсичности и метаболизма подтвердили перспективность соединений, а следующий этап исследований пройдёт на живых организмах.
Работа выполнена при поддержке Минобрнауки России в рамках Десятилетия науки и технологий.




 cookie-studio
cookie-studio

Комментарии читателей
Есть немного, удивительно, но факт. На самом деле у нас много чего есть, но все в зачаточном состоянии. И гвозди у нас производят, хотя сенаторам про то не известно
Да какие публикации, человек не верит в науку, а верит в бабку ведунью, огурец и сила земли, вот его выбор
Как можно обгадится с ковидом если он есть, у меня куча знакомых, родственников переболело, я сам болел. Есть знакомые погибшие от него. Отец нурмагадева умер от ковида и все равно находятся умники утверждающие что ковида нет. А земля у тебя хоть круглая, или тоже врут? Скоро мы на небесную ось налетим, что там пишут в твоих статейках?
Вы позволите узнать количество Ваших публикаций в этом журнале? Или даже в руках не держали?
Nature обгадился с ковидом по самое немогу, ссылаться на него признак тупоумия.